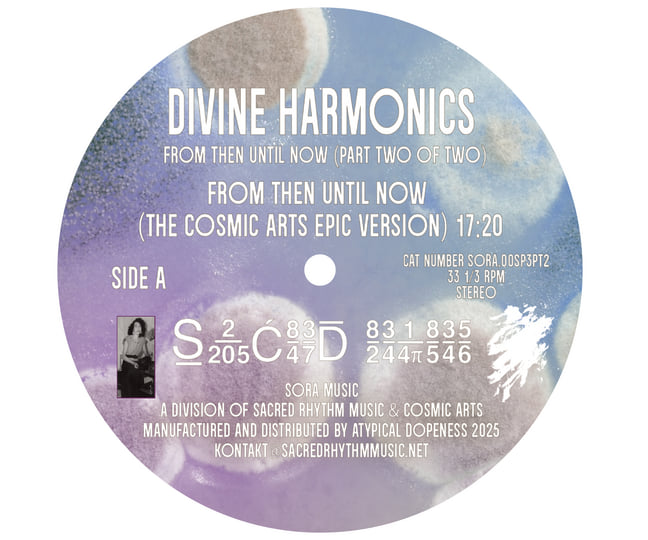
Special Pressing Announcement: Kuniyuki Takahashi & Joaquin Joe

マイストア
変更
お店で受け取る
(送料無料)
配送する
納期目安:
2025.12.30 21:45頃のお届け予定です。
決済方法が、クレジット、代金引換の場合に限ります。その他の決済方法の場合はこちらをご確認ください。
※土・日・祝日の注文の場合や在庫状況によって、商品のお届けにお時間をいただく場合がございます。
その他 Kuniyuki ,Joe Claussell/Divine Harmonics Special Pre-order Announcement: Kuniyuki Takahashi & Joaquin Joeの詳細情報
Special Pre-order Announcement: Kuniyuki Takahashi & Joaquin Joe。DIVINE HARMONICS/KUNIYUKI/クニユキ/極限定商品・片面カラー。Kuniyuki Takahashi & Joaquin Joe Claussell – Divine Harmonics Pt.1。Kuniyuki Takahashi, Joaquin Joe Claussell/Divine Harmonics,From Then Until Now (Part One Of Two)を出品します。。Kuniyuki Takahashi / Joaquin Joe Claussell – Divine Harmonics。未使用ですが個人保管の為nc/nrでお願いします。SORA003PT1Limited
ベストセラーランキングです
近くの売り場の商品
カスタマーレビュー
オススメ度 4点
現在、4570件のレビューが投稿されています。